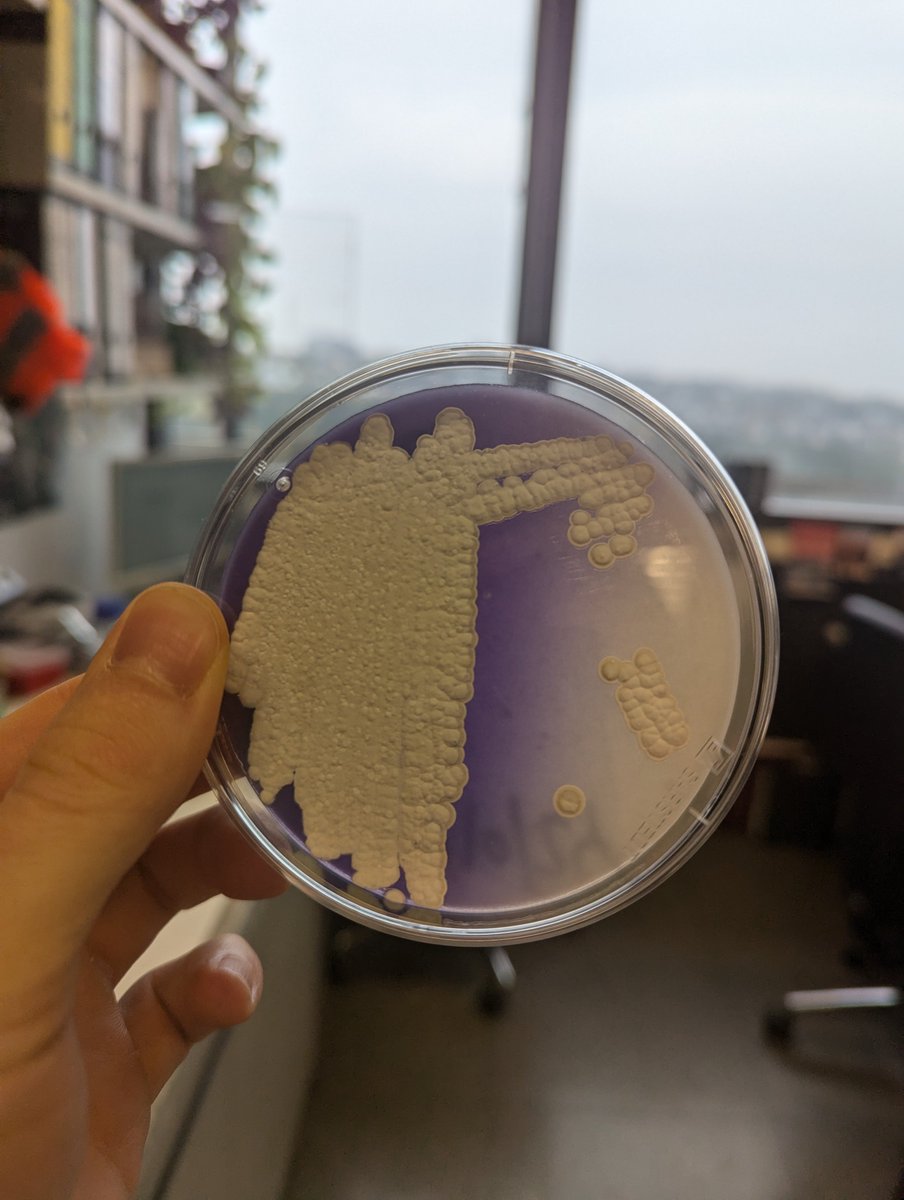
Sam Williams tweet media

Sam Williams retweetledi

TWO postdoc positions in Computational Microbiology and/or biochemistry. Join our interdisciplinary group in the new Life and Mind Building @OxfordBiology, @UniofOxford, @IneosOxford
Please apply and share this post:
jobs.ac.uk/job/DMP641/pos…
English